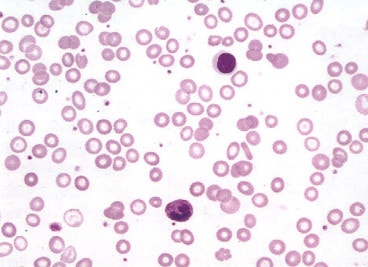
Iron deficiency anemia (IDA, 철결핍성빈혈) : 네이버 블로그

빈혈
빈혈의 분류 및 접근
적혈구의 평균 용적 (MCV)에 따라 분류
소적혈구 빈혈 (MCV <75fL)
대적혈구 빈혈 (MCV >100fL)
정상 적혈부 빈혈 (MCV 75~100fL)
진단 흐름
영아의 생리적 빈혈
원인 및 기전
출생 후 점차 혈색소가 낮아지기 시작하여 6-8주간 지속적으로 낮음
자궁외 생활에 대한 생리적 적응 현상
생후 3개월부터 철분 보충 필요
조산아: 만삭아보다 더 이른 시기 (생후 3~6주)에 혈색소 수치가 7~9g/dL까지 저하
모든 조산아에게 생후 1개월부터 철분요법 시행
생후 3개월 이전에 6.5~7g/dL이하로 떨어지면서 증상이 있거나 동반 질환이 있는 경우 수혈 고려
철결핍빈혈
원인
출생 시 철 저장 부족/철 소실 증가: 조산아, 쌍둥이, 태아 실혈, 분만 시 출혈
철분 섭취 부족: 식사불량/1세 이전 우유 섭취, 만성 설사, 흡수장애
철 수요량 증가: 조산아, 성장속도가 빠른 영아, 사춘기
실혈: 기생충, 소화기 출혈, 월경 과다
증상
피부 및 점막 창백 (anemic conjunctiva)
이식증 (pica)
설염, 입술증, 스푼형 손톱 (koilonychia)
수축기 심잡음, 심비대 등
진단
혈액검사: Hb, MCV, ferritin, iron/TIBC ratio, TfR
PB smear: central pallor 가 증가된 RBC 소견, poikilocytosis, anisocytosis (RDW>15)
치료: 원인 교정 및 경구 철분 요법 (ferrous sulfate)
식사 사이에 섭취 (음식물과 함께 섭취시 흡수 방애)
우유섭취를 하루에 500ml 이하로 제한
반응이 없는 경우: poor compliance, 지속적 출혈, 흡수장애, 엽산/코발라민 결핍 동반, 기타 빈혈질환 등 감별
골수 형성 부전에 의한 빈혈
선천 순적혈구 빈혈 (Diamond-blackfan anemia, congenital hypoplastic anemia)
원인: 리보솜 단백의 돌연변이, 성염색체 열성 유전
임상양상 및 특징
상염색체 우성 유전
생후 수일 내 안면창백, 2-6개월 내 심한 빈혈 발생
작은 키, 태아 수종, 선천 기형 (두개골 안면 기형, 상지/손 기형, 안과, 비뇨기과, 심장 등)
검사소견: HbF 및 적혈구 i 항원 표현 증가
치료: 반복 수혈, 1세 이후에는 스테로이드 반복 치료
후천 순적혈구 빈혈
원인: 바이러스 감염 후 일시적 적혈구 형성 저하증 (parvovirus B19 m/c)
Hereditary spherocytosis, sickle cell anemia 등 만성 용혈질환 환자에게는 골수무형성 위기 초래 가능
Fanconi 빈혈
정의: 선천 범혈구 감소증
임상양상 및 특징
상염색체 열성 유전
10세 전에 발병 (혈소판 감소 → 중성구 감소 → 대적혈구 빈혈)
MDS, AML, 상피암 발생 위험 높음
다양한 신체적 이상/기형 동반: cafe-au-lait spot, 성장장애, 엄지손가락/요골 형성부전, 생식기/생식샘 기능저하 등
진단: DEB를 사용한 림프구 염색체 파손 검사
치료
안정적이고 수혈이 필요하지 않은 경우 경과관찰
수혈이 필요한 경우 조혈모세포 이식 (유일한 완치 방법)
만성 질환에 의한 빈혈 (ACD)
기전 및 원인
지속적인 면역활성화로 인해 발생
감염, 악성종양, 만성 신질환, 자가면역질환, GVHD 등에서 발생
감별
0개의 글
** 제목만 보더라도 어떤 내용인지 알 수 있도록 완성된 문장으로 작성해주세요.
예시) 초음파 (X) → 초음파 사진에서 PDA 소견을 어떻게 알 수 있나요? (O)